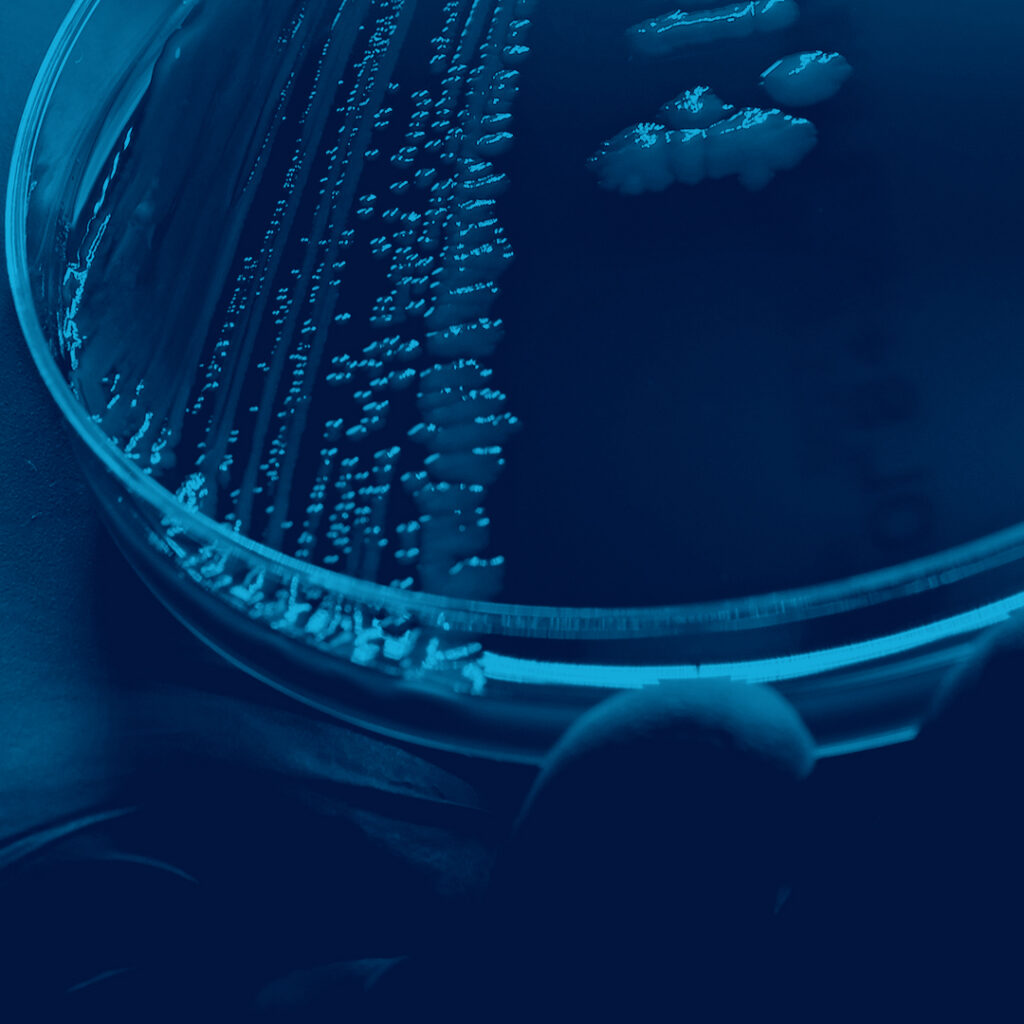
GenomeKey

Case Studies

GenomeKey
How we helped GenomeKey secure a Senior Data Engineer and ML Engineer to power their AI-driven genomics analysis platform.


Ellison Institute of Technology
Building EIT’s data, software and systems engineering teams to power its world-leading AI research mission in Oxford.


Nansen
How we sourced Nansen a Head of Security to strengthen its blockchain platform and lead global information security.


Arcwide
How we built Arcwide’s IFS delivery capability across Europe, securing 29 specialists to strengthen its consulting, architecture and project delivery teams.


Rowden Technologies
How we helped Rowden build the technical and leadership team behind its defence-focused edge-intelligence platform.


Jua
How we secured a senior AI researcher to drive Jua's AGI roadmap and accelerate the development of its climate modelling platform.


Instadeep
How we helped secure research, ML, computational biology and operational teams across the UK, France and Germany.


General Autonomy
How we hired General Autonomy its first ML Robotics Scientists to build its foundational robot-learning team.


Kinomica
How we sourced a highly specialised phosphoproteomics expert for Kinomica, a fastscaling, UK-based cancer diagnostics firm.


Brain Corp
How we helped Brain Corp hire a senior SLAM specialist to advance its autonomous robotics systems and accelerate product development.


Swarm Biotactics
How we delivered a senior electronics hire to remove hardware bottlenecks and advance development of Swarm's next-generation bio-robotic systems.


Epic Games / Cubic Motion
How we’ve helped Cubic Motion and Epic Games scale specialist software, computer vision, and production teams across Europe and North America.


Lilium
How we helped Lilium rapidly scale its engineering and production capability by delivering over 200 specialist contractors during a critical phase of aircraft development.


ShareChat
How we built the foundational AI and ML teams to support social media firm ShareChat's global expansion.